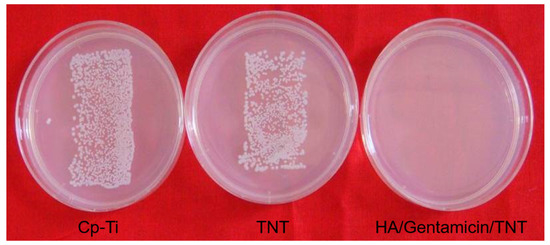

Abstract
The antibacterial properties of titanium make it useful for clinical applications. Hydroxyapatite (HA) is widely utilized as a coating on orthopedic implants to improve osteointegration. Titanium oxide nanotubes (TNT) are recognized as a promising solution for local antibiotic therapy in bone implants. It is demonstrated that the utilization of HA-coated titanium can improve the biocompatibility of bone implants. This research aims to examine the antibacterial properties and biocompatibility of the TiO2 nanotubes by loading HA and gentamicin. In vitro testing, the characterization of drug release, cell adhesion and proliferation, bacteria culture, and antibacterial tests were conducted. During the in vivo experiments, Staphylococcus aureus was implanted into the femur of rats. The animals were sacrificed at four weeks followed by microbiological and clinical assessments on the bone, which were conducted by removing the implants followed by agar plating. The in vitro cell incubation demonstrated that the TiO2 nanotubes loaded with hydroxyapatite and gentamicin had better cellular compatibility compared to Cp–Ti. In addition, in vitro elution testing showed that gentamicin was released from the hydroxyapatite/TiO2 nanotubes for as long as 22 days. The release time was much longer than the TNT loaded with gentamicin at only 6 h. All animals in the gentamicin/HA/TNT group were free of infection compared to those in the Cp–Ti, TNT, and HA/gentamicin/TNT groups. There was a considerable reduction in the rates of infection among the rats with gentamicin-HA-TNT coatings compared to standard titanium. These results indicated that the co-precipitation of gentamicin and HA loading using the TNT method provided a novel prophylactic method against prosthetic infections and other biomedical applications.
1. Introduction
Titanium (Ti) and its alloys are widely used as orthopedic implants due to their superior biocompatibility, good mechanical properties, and excellent corrosion resistance [1]. However, the relatively small number of antibacterial properties of the Ti shorten its lifetime for clinical applications. Despite strict antiseptic operative procedures, infection after joint replacement occurs in 2–4% of cases [2], but infection rates can be up to 30% in external fixation systems [3]. Hence, it is important to improve antimicrobial prophylaxis in orthopedic implant surgeries.
There are multiple methods regarding the surface biological activation of titanium and titanium alloys, mainly divided into physical, chemical, and electrochemical methods. The physical method is utilized by preparing active coating/titanium composites by coating them with phosphate or injecting calcium or other elements to introduce a bioactive coating on the surface of the titanium. Under physiological conditions, titanium and bone tissue form a bond through the coating or other phosphates. For example, the dip-coating method is relatively simple and easy to carry out, but the bonding strength between the coating and substrate is not high. A possible alternative physical method includes the plasma spraying method. The chemical method is utilized to chemically modify the surface of the titanium and titanium alloy for bioactivity. Soaking the materials in simulated body fluid or planting in the animal bone positions forms the surface bone-like phosphor limestone layer. Other examples of the chemical method include the sol-gel method, alkali heat treatment method, and more. The common advantage of this method is that the equipment used is simple and inexpensive. A disadvantage of a uniform coating on the surface of materials with complex shapes is that the steps are complex and time-consuming. The third method utilizes the electrochemical deposition for metal deposition in the interface between the electrode and electrolyte solution under the action of an electric field. This method is simple and universal as the prepared nanostructures have good uniformity. However, the equipment required is expensive and is complex to use.
The principle of locally delivering antibiotics during orthopedic surgery is proven to decrease infection rates significantly. For example, producing bone cement mixed antibiotics is one such method [4,5,6]. However, the need for the localized delivery of antibiotics by cementless orthopedic implants remains a challenge for clinicians abroad. Over the past few years, TiO2 nanotubes received considerable attention as a potential material to improve the osseointegration and as a potential drug delivery system [7,8,9,10,11,12,13,14].
Research illustrated that HA-coated titanium implants can improve the biocompatibility of implants [15,16,17]. The TiO2 nanotubes loaded with antibiotics and HA may be used as biomaterial implants to increase the osseointegration and reduce implant-related infections [18,19]. In a previous study, we incorporated antibiotics into TiO2 nanotubes through simple absorption. However, this resulted in an unfavorably fast release time from the nanotubes, which was less than 4 h [11]. In this study, HA and gentamicin were loaded into TiO2 nanotubes via a co-precipitation drug loading method and were tested through novel in vivo and in vitro methods. It was also further explored whether the treated tube layers showed an improved antibacterial efficacy and prolonged drug release.
2. Materials and Methods
2.1. Sample Preparation
The titanium substrates were utilized to fabricate nanotubes (99.9% pure, Alfa Aesar, Ward Hill, MA, USA). Then, these nanotubes were cut into rods (with a height of 20 mm and a diameter of 1 mm) and plates (1 cm × 1 cm ×1 mm) from the titanium substrate by mechanical cutting. Fabrication of the TiO2 nanotubes was completed through an anodization process that was formerly explained [11]. Through this process, the plates were used as anodes, while a platinum electrode was used as the cathode. The electrolyte used in the experiment contained 0.5 vol % of hydrofluoric acid in water. Subsequently, the anodization took place for 30 min at ambient temperature and a constant voltage of 20 V. After that, the specimens were washed by sonication in deionized water and dried in an oven at 60° after completing the anodization process.
2.2. Drug Loading by Co-Precipitation
The specimens were purified in deionized water ultrasonically. Next, the nanotube specimens were soaked in 20 mL of 1.5× simulated body fluid (SBF, containing 9.086 g (CH2OH)3CNH2, 0.107 g NaSO4, 0.417 g CaCl2, 0.458 g MgCl2·6H2O, 0.342 g K2HPO4·3H2O, 0.336 g KCl, and 0.525 g NaHCO3 in 1000 mL dH2O, pH 7.35) at room temperature for 3–5 days. After soaking, the specimens were removed from the SBF solution and dried at room temperature for 24 h. Then, gentamicin was loaded using the lyophilization method [11], wherein a solution was prepared by dissolving 1000 mg of gentamicin in 10 mL of phosphate-buffered saline (PBS; Sigma) solution equivalent to 100 mg/mL. The implant surface was thereafter pipetted with 20 μL of the antibacterial solution. This was followed by gently shaking the implants to ensure that the antibiotic solution was distributed uniformly throughout the surface. Afterward, drying of the materials was completed at ambient temperature for 1 h. Once the drying process was complete, the loading step was performed once more ensued by the adjustment of the surface gentamicin concentration to 500 µg/cm2.
2.3. Characterization of Substrates
The sample surfaces of the Cp–Ti nanotubes and HA/Ti nanotubes were characterized via field emission SEM (Hitachi, S4800, Tokyo, Japan). This microscope was fitted with an energy dispersive X-ray analysis (EDX) attachment and was used at an accelerating voltage of 20 kV. All non-conductive specimens were sputter-coated with Au-Pd utilizing a sputter-coater for 2 min prior to imaging.
2.4. Drug Release
An in vitro experiment was performed to test the release of gentamicin kinetics from the surface of the samples. The samples were shifted to a fresh 12-well plate and were incubated in 1 mL PBS (Sigma) at room temperature as the immersion of the TNT/gentamicin and TNT/HA/gentamicin TNT implants in 500 μL of PBS led to the release of gentamicin. The release kinetics were determined by taking aliquots (300 μL) of the solution at specific time intervals. The solutions were replaced with 300 μL of fresh PBS every time samples were taken. An ultraviolet spectrophotometer (Nano-Photometer®®; Implen, Munich, Germany) was utilized to analyze the drug concentration at the wavelength of 237 nm.
2.5. Biocompatibility Assays
Mouse osteoblasts (MC3T3-E1) were obtained from the American Type Culture Collection (CRL-2593). Culturing of the osteoblasts was conducted in a humid environment at a temperature of 37 °C and 5% CO2 concentration using an α-medium containing 10 percent fetal bovine serum (Hyclone) without antibiotics. Each day, the complete medium was replenished and confluent cells were further sub-cultured through trypsinization.
2.6. Cell Adhesion and Proliferation
All samples (6 samples per implant type) were decontaminated using ethylene oxide and then kept in plastic Petri dishes containing 12-well plates (Corning, New York, NY, USA). The response of the osteoblasts was investigated on Ti, TNT, and HA/TNT/gentamicin plates (1 cm × 1 cm) at an initial seeding concentration of 1 × 104 cells/cm2 within the 12-well plates. This was followed by culturing of the cells at a temperature of 37 °C in a humid environment and 5% CO2. The osteoblast adhesion was investigated after 6 h and 24 h. Cell proliferation was investigated after 3 and 5 days. The samples were observed via SEM at a hastening voltage of 20 kV. This was followed by the counting of, the cells that were attached to 3 random fields of view (the size of each field equivalent to 1 mm2) per substrate utilizing the Image-Pro Plus 6.0 software (Media Cybernetics, Rockville, MD, USA). The average cell number (cells/mm2) was reported.
2.7. Bacterial Culture and Antibacterial Assay In Vitro
The antibacterial ability of these materials was evaluated using Staphylococcus aureus (S. aureus, ATCC 25923). Culturing of the S. aureus was conducted in the Luria-Bertani (LB) agar plates. Prior to the inoculation of bacteria onto the plates, the S. aureus was cultured in the LB medium at a temperature of 37 °C for a duration of 24 h. The concentration of the bacteria was measured through an optical density measurement. For the antibacterial assays, the concentration was adjusted to 108 CFU/mL in the in vivo experiment and 107 CFU/mL in the in vitro experiment, respectively.
Bacterial adhesion was investigated on titanium (Ti), TNT, and HA/gentamicin/TNT where all the substrates had the dimensions of 1 cm × 1 cm. After extensive washing with sterile distilled water, each specimen was grown in 1 mL of the bacterial suspension (107 CFU/mL) in LB medium at a temperature of 37 °C. At the end of incubation at 2 and 6 h, the sample was removed from the culture medium. Then, the implants were gently rinsed with PBS. Bacterial adhesion and colony formation were then assessed using SEM. Fixing of the specimens was completed in 2.5 percent glutaraldehyde and then dehydrated with increasing ethanol concentrations (75%, 80%, 90%, 95%, and 100%, 15 min each). The specimens were examined utilizing SEM to investigate the development of biofilm following critical point drying and sputter coating with gold.
2.8. Surgical Procedure and Implantation
Approval of all the experimentation procedures was obtained from the Animal Care Committee of China Medical University. For the in vivo assay, an SD rat model was utilized for 30 days. The tests were conducted on male Sprague Dawley rats that were 3-months old and weighed between 300–350 g. All rats were given access to standard water and rat chow ad libitum. The environment was air-conditioned with a controlled 12-h light/dark cycle throughout the study with a maintained temperature and humidity. All the rats used in the experiment were randomly categorized into 3 different groups (n = 20). The control group (n = 10) had rats with Cp-Ti implants with femoral bone marrow cavities contaminated with bacteria (107 CFUs). Then another group of rats (n = 10) had their femoral canals implanted with (TNT) rods containing the bacterial inoculum (107 CFUs). The third group of rats was implanted with HA-gentamicin-rods in the femoral canal, which contained the bacterial inoculum (107 CFUs).
Based on an animal study explained previously [11], male Sprague-Dawley rats aged 8-weeks with each weighing between 250–300 g each were anesthetized via injection with ketamine (80 mg/kg) and xylazine (10 mg/kg). In all the samples, an implant was provided for the right femurs. After shaving, the right leg was washed with a 10 percent povidone-iodine solution. A skin incision was then used to gently expose the distal part of the femur. The femoral intercondylar fossa was then approached using a 1 cm anteromedial incision to expose the femoral intercondylar fossa. Kirschner pins (diameter, 1 mm) were drilled to create a channel from the femoral intercondylar fossa into the medullary canal at a low speed of 800 rpm. The rods were then implanted while a bacterial suspension of S. aureus (107 CFUs) was injected into the femoral canal via the perforation. Then, the holes were closed using bone wax, followed by closing the fascia and subcutaneous layers using sutures. An X-ray was then conducted postoperatively.
After a timeframe of 4 weeks, the rats were sacrificed. Microbiological and histological methods were then performed to detect the infection. Approval of this protocol was given by the Local Animal Committee (Shen Yang, China Medical University) and was carried out as per the national guidelines for the care and use of laboratory animals.
2.9. Standard Agar Plating
The rats were sacrificed 28 days post-surgery and their femurs were split into 2 sections longitudinally. The rods were then removed carefully from the femoral canals in a sterile manner. The bone specimens were collected via swabs from the tissues encircling the rods. These tissue swabs were then weighed and placed into a tissue grinder. Afterward, the swabs were loaded into brain heart infusion (BHI) agar plates followed by incubation at a temperature of 37 °C for a duration of 24 h. Counting was completed to determine the number of CFUs on each plate which was then presented as CFU/mg (total weight of each sample). The quantity of CFUs in each sample was determined by calculating the average of all three dilutions.
2.10. Statistical Analyses
SPSS 13.0 software (IBM, Armonk, NY, USA) was utilized for statistical analysis, which included the Student’s t-test. The statistical significance was set at p < 0.05. The hypothesis stated that HA/gentamicin/TNT coating could lower the rates of infection by 50 percent.
3. Results
3.1. Surface Morphology of the Implants
From the SEM observation, the anodization on the titanium surface led to the formation of TiO2 nanotube layers on the titanium substrates. An organized tube array was displayed in the top view and cross-sectional layers, with an average layer thickness of 4 μm and an average diameter of around 80 nm (Figure 1).

Figure 1.
Scanning electron microscope images of anodized nanotubular titanium. The top view (A,B) and cross-section (C) of the layers display an organized tube array with an average thickness of the layer of 4 μm tube and an average diameter of around 80 nm.
After soaking the TiO2 nanotube samples in the SBF mixed with gentamicin, the surface was completely covered by a dense crystalline layer. The treatment resulted in the development of crystalline residues, as illustrated when the SEM images after treatment are compared. To determine the chemical as well as structural characteristics of the residues (Figure 2A,B), EDX analyses showed that the elements Ca and P were present in the coating on the surface of the TNT (Figure 2C).

Figure 2.
Scanning electron microscope images and EDX analysis of anodized titanium coated with gentamicin and in simulated body fluid. (A,B )show the TNT samples soaked in SBF for 24 h and 72 h. (C) shows EDX analysis of the coating that uncovered the presence of P and Ca in the coating placed onto the anodized titanium surface. Scale bars = 200 nm.
3.2. Drug Release
There was an observed difference in the drug release rate, as the release appeared to last relatively longer with the co-precipitation approach as opposed to the simple drug loading method. In the TNT/gentamicin group prepared using the simple loading method, there was a significant drug release within the first two hours but had very little drug release after reaching the 4-h time point (Figure 3). In contrast, there was a relatively slower and longer release time (more than 22 days) in the HA/gentamicin/TNT group prepared through the co-precipitation method. Moreover, the release profile of gentamicin from the HA/gentamicin/TNT setup showed continuous release in a regulated way: 36% release in the first 6 h, 55% release after three days, 73% release after seven days, and approximately 100% release after 22 days (Figure 3). On the other hand, the gentamicin from TNT showed an initial burst of release that lasted for approximately 4 h (Figure 3).

Figure 3.
The drug release kinetics of the TNT/Gentamicin and HA/Gentamicin/TNT. Data = mean ± SD, N = 3.
3.3. Cell Morphology, Adhesion, and Proliferation
To investigate cell behaviors on the Ti, TNT, and HA/gentamicin/TNT substrates, we first observed the morphologies of the mouse osteoblasts through SEM. Figure 4A,D revealed that the mouse osteoblasts grown on the flat Ti substrate did not appear to be anchored as the pseudopodium seemed to be detached from the surface at day 1. On the other hand, the mouse osteoblasts on the TNT surface seemed better anchored than on the bare Ti as the filopodia formed a more extended structure and a higher extent of contact on the TNT (Figure 4B,E) and HA/gentamicin/TNT surfaces (Figure 4C,F). Compared to the Cp-Ti surface, multiple filopodia were more extended along the HA/gentamicin/TNT-coated surface.

Figure 4.
SEM micrographs showing osteoblast filopodia growth on (A) Cp–Ti, (B) TNT, and (C) HA/Gentamicin/TNT substrates after 72 h. Greater SEM micrographs magnification of osteoblasts on (D) Cp–Ti, (E) TNT, and (F) HA/Gentamicin/TNT surfaces revealed a far more prominent filopodia protrusion, a more extended structure, and an elevated level of contact with the TNT and HA/Gentamicin/TNT when contrasted with those on the Cp–Ti substrate.
Osteoblasts were tracked utilizing SEM to determine the cell adhesion and proliferation of the various Ti substrates. The cells tended to proliferate and extend throughout time, independent of the substratum type. With the increase in the number of cells over time they became increasingly proliferative, and the rate of adhesion was seen as per the order indicated below: HA/gentamicin/TNT ≈ TNT > Cp–Ti (Figure 5).

Figure 5.
Cell adhesion increased in the TNT and HA/Gentamicin/TNT groups compared to the Cp–Ti group at 6 and 24 h. At three and five days, the cells of the TNT group and HA/Gentamicin/TNT groups had higher proliferation rates compared to the Cp–Ti group. Data = mean ± SD, N = 3.
3.4. Antibacterial Ability In Vitro
Cp–Ti, TNT, and HA/gentamicin/TNT samples were examined for bacterial adhesion (Figure 6). We discovered in this investigation that bacterial adhesion to the surface of NT was decreased by TNT use. We observed that not all the bacteria were killed by the NTs. However, on NT or NT–V surfaces (Figure 6C,F), the bacterial morphology was compromised, as revealed via SEM. In comparison with the NT group as well as the Cp–Ti group, the bacterial adherence was statistically and substantially reduced in the NT–V group. After 6 h, SEM pictures of the colonies of bacteria were displayed on Ti (Figure 6A), TNT (Figure 6B), and HA/gentamicin/TNT (Figure 6C). On Cp–Ti, the bacteria were found to have natural morphology as shown by the white arrow (Figure 6D) and on TNT as shown by the red arrow (Figure 6E). Nevertheless, the morphology of bacteria was compromised when grown on gentamicin-loaded NTs, as indicated by the green arrow (Figure 6F).

Figure 6.
Figure (A–E) Antibacterial efficacy in vitro. SEM pictures of colonies of bacteria after 6 h on (A) Ti, (B) TNT, and (C) HA/gentamicin/TNT. The bacteria exhibited a typical morphology on (D) Cp–Ti (white arrow) and (E) TNT (red arrow). However, the morphology of bacteria was compromised when grown on the (F) gentamicin-loaded NTs (green arrow).
3.5. Antibacterial Ability In Vivo
The post-surgical X-ray results revealed that the rods were correctly placed intramedullary in the femurs of all rats (Figure 7). During surgical procedures, none of the rats were lost. The clinical symptoms of purulent infections were shown by all animals inside the Cp–Ti group and 9 of 10 in the TNT group. None of the rats in the HA/gentamicin/TNT group had signs of infection at four weeks’ post-operation.

Figure 7.
Surgical procedure and antibacterial efficacy in vivo. (A) HA/gentamicin/TNT rods (B,C) postoperative X-ray with the implanted titanium rods in the tibia of rats.
3.6. Agar Plating
There was a significant correlation between the agar plates obtained from the rats that exhibited clinical symptoms consistent with an infection (Figure 8). When the positive culture growth was observed on the agar plates of the rolled-out rods, it was discovered that the matching bone specimens from the same rats were also growing. Infection rates were observed to be at 100% for the bare Ti group and 92% for the TNT group, whereas there was no infection in the HA/gentamicin/TNT group. There was a statistically considerably lowered infection rate in the HA/gentamicin/TNT group as opposed to the TNT and bare Ti groups, while no significant difference was detected between the TNT group and bare Ti group.
Figure 8.
Infection rates were observed to be at 100% for the bare Ti group and 92% for the TNT group. A 0% infection rate was observed for the HA/gentamicin/TNT group. There was a significantly reduced infection rate in the HA/gentamicin/TNT group compared to the TNT and bare Ti groups.
4. Discussion
Implant infection has widely been recognized as one of the most severe problems that can occur after orthopedic surgery. The current strategies for preventing infection include the systemic administration of high doses of antibiotics and bone cement loading with antibiotics. However, the systemic administration of antibiotics has many shortcomings, including poor bioavailability, low effectiveness, and systemic toxicity, which makes them ineffective [20]. The delivery of antibiotics in a localized area is considered safer and more effective than systemic administration [4,5,6]. Artificial joints that are fixed with antibiotic-loaded bone cement can significantly decrease implant infection [6]. However, the currently used orthopedic implants are cementless. Infection prophylaxis by using local antibiotics in cementless implants has not yet been established clinically. According to the findings of Ercan et al. [21], NTs have a strong antibacterial impact due to the presence of inorganic residues like TiF4 during anodization. However, in our previous study [11], we discovered that the NTs had lower bacterial adhesion (approximately 40%) onto NT surfaces contrasted with that of the Cp–Ti, while their antimicrobial effect was impaired when the nanotubes were covered with proteins or inorganic substances. The current study is the first to report the use of the TNT coating with HA and gentamicin in vivo.
Gentamicin is a heat-stable antibiotic commonly utilized in culture media and various other applications. It is an aminoglycoside drug mainly used to treat bacterial infections, including those caused by Staphylococcus. It is one of the main antibiotics used in clinical application because of its low price and broad indications. Staphylococcus aureus is one of the primary pathogens present in orthopedic surgery infections. Therefore, gentamicin and S. aureus were chosen to mimic the effectivity of the method presented during infection.
This paper described bacterial adhesion onto different Ti-based substrates after 24 or 48 h. In addition, it also examined their antibacterial properties in vivo through a more extended period of up to 4 weeks. Significantly reduced infection rates were observed in the gentamicin-HA-TNT coating compared to the standard titanium. All animals in the HA/gentamicin/TNT group remained infection-free regardless of the high inoculation dosage with 107 CFU S. aureus. The co-precipitation drug loading technology, which was utilized at room temperature on the TNT layers, allowed for the development of biologically active antibiotics.
The biocompatibility of the HA/gentamicin/TNT samples was evaluated using cell culture techniques. Many studies demonstrated that TiO2 nanotubes enhanced cell function and allowed the filopodia of growing cells to move into the nanotube pores, leading to an increased spread and propagation [9,10,11]. Protein adsorption, osteoblast proliferation, and differentiation into functional tissue were all shown to be affected by morphology. HA/gentamicin/nanotubular coatings improved the function of osteoblasts at the initial phase of bone development. The HA/gentamicin/TNT group was found to have a better cellular biocompatibility than the Cp–Ti group.
Figure 2 depicts the drug release patterns of gentamicin loaded into the TiO2 nanotubes, displaying the release efficacy (% of drug release) at different intervals of time. The release profile of gentamicin from HA/gentamicin/TNT showed that it was continuously released in a regulated way: 41% release in 6 h, 57% release in three days, 75% release in 7 days, and almost 100% release in 22 days (Figure 3). In contrast, in the TNT/gentamicin group prepared by simple loading methods, there was a rapid drug release within the first four hours but it had a minimal release afterward. Hence, the co-precipitation drug loading method can avoid the burst release of the drug and can extend the TNT implant drug release. Numerous studies showed that there were several methods for extending medication release from TNT implants including surface modification and polymer coating to extend the release of drugs for more than 30 days [13,19]. Here, we demonstrated the potential of incorporating commonly used antibiotics into TNT on the surface of a Ti-based implant compared to the utilization of a simple soaking technique.
Hydroxyapatite has a microstructure similar to human bone tissue. New bone tissue can grow into the material along the surface of the implanted material, allowing its combination with bone tissue. The advantages of a local drug delivery system include: drug release at the affected area, the drug concentration is rapidly reached locally, maintenance of the local effective drug concentration for longer durations, and the prevention of adverse reactions caused by the systemic application of antibiotics. This prevents the disadvantage of local loss of blood supply after a bone defect [22]. Therefore, there was a significant decrease in the rates of infection in the gentamicin/HA/TNT group contrasted with that of the standard Cp–Ti group and TNT group. Gentamicin/HA/TNT had good prophylaxis and enhanced the biocompatibility and antimicrobial activity both in vivo and in vitro. Therefore, HA/TNT loaded with gentamicin could be potentially used as an implanted biomaterial to enhance the function of osteoblasts and reduce implant-associated rates of infection in orthopedics.
5. Conclusions
This study is the first to provide in vitro and in vivo findings on TNT coating HA and gentamicin. In this study, TiO2 nanotubes loaded with HA and gentamicin can achieve the dual aim of preventing bacterial adhesion and proliferation in vivo and in vitro, whilst retaining the nanostructured surface’s osseointegration characteristics (without a negative effect). The gentamicin-HA-TNT coating significantly reduced the infection rates compared to standard titanium. Furthermore, the HA-gentamicin-TNT was shown to have a longer drug release time of up to 3 weeks. The TiO2 nanotubes, loaded with gentamicin and HA may be used as a biomaterial implant to increase osseointegration and reduce implant-related infections. These results indicated that the Co-precipitation of gentamicin and the HA loading on the TNT method promises a novel avenue for the development of prophylaxis against prosthetic infections and will have considerable utility in biomedical applications.
Author Contributions
S.T.: writing; X.S.: literature search, figures; A.W.: data collection, data analysis; S.G.: data interpretation; H.Z.: study design. All authors have read and agreed to the published version of the manuscript.
Funding
This research was conducted with the support of the National Natural Science Foundation of China (51872332 and 81501857), China Postdoctoral Science Foundation Project (2018M641741), Natural Science Foundation of Liaoning Province (2019-BS-281, 2019-MS-377).
Institutional Review Board Statement
The study was conducted according to the guidelines of the Declaration of Helsinki, and approved by the Ethics Committee of China Medical University (protocol code: CMU20211277 and date of approval: 11 June 2021).
Informed Consent Statement
Not applicable.
Data Availability Statement
No new data were created or analyzed in this study. Data sharing is not applicable to this article.
Conflicts of Interest
The authors declare that there are no conflict of interest.
References
- Yao, C.; Perla, V.; Mckenzie, J.L.; Slamovich, E.B.; Webster, T.J. Anodied Ti and Ti6Al4V possessing nanometer surface features enhances osteoblast adhesion. J. Biomed. Nanotechnol. 2005, 26, 4516–4522. [Google Scholar]
- Thomes, B.; Murray, P.; Bouchier-Hayes, D. Development of resistant strains of Staphylococcus epidermidis on gentamicin-loaded bone cement in vivo. J. Bone Jt. Surg. Br. 2002, 84, 758–760. [Google Scholar]
- Green, S.A. Complications of external skeletal fxation. Clin. Orthop. Relat. Res. 1983, 180, 109–116. [Google Scholar]
- Wu, P.; Grainger, D.W. Drug/device combinations for local drug therapies and infection prophylaxis. Biomaterials 2006, 27, 2450–2467. [Google Scholar] [CrossRef]
- Diefenbeck, M.; Mückley, T.; Hofmann, G.O. Prophylaxis and treatment of implant-related infections by local application of antibiotics. Injury 2006, 37 (Suppl. 2), S95–S104. [Google Scholar] [CrossRef]
- Marta, V.; Zdenek, T.; Premysl, V.; Vaclav, N. Beta-titanium alloy covered by ferroelectric coating-physicochemical properties and human osteoblast-like cell response. Coatings 2021, 11, 210. [Google Scholar]
- Eaninwene, G., II; Yao, C.; Webster, T.J. Enhanced osteoblast adhesion to drug-coated anodized nanotubular titanium surfaces. Int. J. Nanomed. 2008, 3, 257–264. [Google Scholar]
- Losic, D.; Simovic, S. Self-ordered nanopore and nanotube platforms for drug delivery applications. Expert Opin. Drug Deliv. 2009, 6, 1363–1381. [Google Scholar] [CrossRef]
- Popat, K.C.; Eltgroth, M.; Latempa, T.J.; Grimes, C.A.; Desai, T.A. Decreased Staphylococcus epidermis adhesion and increased osteoblast functionality on antibiotic-loaded titania nanotubes. Biomaterials 2007, 28, 4880–4888. [Google Scholar] [CrossRef]
- Simovic, S.; Losic, D.; Vasilev, K. Controlled drug release from porous materials by plasma polymer deposition. Chem. Commun. 2010, 46, 1317–1319. [Google Scholar] [CrossRef]
- Zhang, H.; Sun, Y.; Tian, A.; Xue, X.X.; Wang, L.; Alquhali, A. Improved antibacterial activity and biocompatibility on Gentamicin-loaded TiO2 nanotubes: In vivo and in vitro studies. Int. J. Nanomed. 2013, 8, 4379–4389. [Google Scholar] [CrossRef] [Green Version]
- Horkavcová, D.; Doubet, Q.; Jablonská, E. Development of adhesive, bioactive and antibacterial titania Sol-Gel coating on Titanium substrate by dip-coating technique. Coatings 2021, 11, 243. [Google Scholar] [CrossRef]
- Gulati, K.; Ramakrishnan, S.; Aw, M.S.; Atkins, G.J.; Findlay, D.M.; Losic, D. Biocompatible polymer coating of titania nanotube arrays for improved drug elution and osteoblast adhesion. Acta Biomater. 2012, 8, 449–456. [Google Scholar] [CrossRef]
- von Wilmowsky, C.; Bauer, S.; Lutz, R.; Meisel, M.; Neukam, F.W.; Toyoshima, T. In vivo evaluation of anodic TiO2 nanotubes: An experimental study in the pig. J. Biomed. Mater. Res. B Appl. Biomater. 2009, 89, 165–171. [Google Scholar]
- Capello, W.N.; D’Antonio, J.A.; Feinberg, J.R.; Manley, M.T. Ten-year results with hydroxyapatite-coated total hip femoral components in patients less than fifty years old. A concise follow-up of a previous report. J. Bone Jt. Surg. Am. 2003, 85, 885–889. [Google Scholar] [CrossRef]
- Capello, W.N.; D’Antonio, J.A.; Jaffe, W.L.; Geesink, R.G.; Manley, M.T.; Reinberg, J.R. Hydroxyapatite-coated femoral component: 15 –year minimum follow-up. Clin. Orthop. Relat. Res. 2006, 453, 75–80. [Google Scholar] [CrossRef]
- Tsuchiya, H.; Macak, J.M.; Müller, L.; Kunze, J.; Müller, F.; Greil, P. Hydroxyapatite growth on anodic TiO2 nanotubes. J. Biomed. Mater. Res. A 2006, 77, 534–541. [Google Scholar] [CrossRef]
- Zhang, C.Q.; Zhang, L.; Liu, L. Mechanical behavior of a titanium alloy scaffold mimicking trabecular structure. J. Orthop. Surg. Res. 2020, 15, 40. [Google Scholar] [CrossRef] [Green Version]
- Yao, C.; Webster, T.J. Prolonged antibiotic delivery from anodized nanotubular titanium using a co-precipitation drug loading method. J. Biomed. Mater. Res. B Appl. Biomater. 2009, 91, 587–595. [Google Scholar] [CrossRef]
- Cabanillas, P.F.; Díez Peña, E.; Barrales-Rienda, J.M.; Frutos, G. Validation and in vitro characterization of antibiotic-loaded bone cement release. Int. J. Pharm. 2000, 209, 15–26. [Google Scholar] [CrossRef]
- Ercan, B.; Taylor, E.; Alpaslan, E.; Webster, T.J. Diameter of titanium nanotubes influences anti-bacterial efficacy. Nanotechnology 2011, 22, 295102. [Google Scholar] [CrossRef] [PubMed]
- Li, L.; Chen, Y.; Lu, Y.; Qin, S.; Huang, G.; Huang, T.; Lin, J. Effect of heat treatment on the corrosion resistance of selective laser melted Ti6Al4V3Cu alloy. J. Mater. Res. Technol. 2021, 12, 904–915. [Google Scholar] [CrossRef]
Publisher’s Note: MDPI stays neutral with regard to jurisdictional claims in published maps and institutional affiliations. |
© 2021 by the authors. Licensee MDPI, Basel, Switzerland. This article is an open access article distributed under the terms and conditions of the Creative Commons Attribution (CC BY) license (https://creativecommons.org/licenses/by/4.0/).